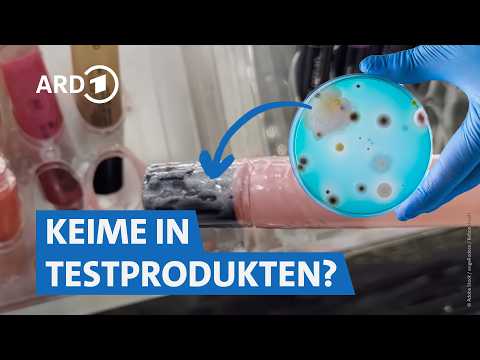
Rossmann, dm & Müller: Preise, Qualität und Hygiene im Check I Die Tricks NDR

About 298 results for "UCxec_VgCE-5DUZ8MocKbEdg"
Featured Results

Beschichtete Pfannen: Welche ist gut und langlebig? 🍳 | Preiswert, nützlich, gut? SWR
ARD MarktcheckFeb 27, 2025
Blitzer-Apps & Gadgets: Das MÜSST ihr wissen! 🚨| FYI – unsere Recherche, Dein Vorteil NDR
ARD MarktcheckFeb 26, 2025
DAS solltet ihr über Wärmepumpen wissen! Kosten, Förderung & Einbau🔌| Preiswert, nützlich, gut? SWR
ARD MarktcheckFeb 23, 2025
Botox, Haartransplantation & Co.: Was kostet (künstliche) Schönheit? | Ausgerechnet WDR
ARD MarktcheckFeb 22, 2025
PT29M24S
So erkennst du unseriöse Finanzberater – auch in deinem Umfeld!🚨 | Echt? WDR
ARD MarktcheckFeb 7, 2025
Linsen - der beste vegane Fleischersatz? (mit leckeren & proteinreichen Rezepten) | Marktcheck SWR
ARD MarktcheckJan 27, 2025
Undercover: So mies sind die Methoden beim Glasfasernetz-Verkauf | Voss & Team MDR
ARD MarktcheckJan 25, 2025
Interdentalbürsten von TePe, Curaprox & Co.: Damit reinigt ihr am besten ✅ | Servicezeit WDR
ARD MarktcheckJan 14, 2025
Walnüsse von Lidl, Aldi, Seeberger, dm & Co.: Welche sind die besten? 🤔| SUPER.MARKT rbb
ARD MarktcheckJan 1, 2025
Parfum von Dior, Chanel und Co. - Wie gut sind die Duftzwillinge? | Ausgerechnet WDR
ARD MarktcheckDec 23, 2024
Ärger mit E-Auto aus China: MG 4 monatelang nicht repariert😶🚘 | Voss & Team MDR
ARD MarktcheckDec 22, 2024
PT43M47S
Rossmann, dm & Müller: Preise, Qualität und Hygiene im Check I Die Tricks NDR
ARD MarktcheckDec 14, 2024
PT9M36S
Neo-Nail, Morovan & Co.: So gefährlich sind DIY-Sets zum Nägel selber machen💅| WDR Markt
ARD MarktcheckDec 10, 2024Swipe to view more pages